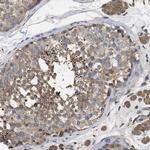
RNF216 Antibody in Immunohistochemistry (Paraffin) (IHC (P))

Search
Invitrogen
RNF216 Polyclonal Antibody
{{$productOrderCtrl.translations['antibody.pdp.commerceCard.promotion.promotions']}}
{{$productOrderCtrl.translations['antibody.pdp.commerceCard.promotion.viewpromo']}}
{{$productOrderCtrl.translations['antibody.pdp.commerceCard.promotion.promocode']}}: {{promo.promoCode}} {{promo.promoTitle}} {{promo.promoDescription}}. {{$productOrderCtrl.translations['antibody.pdp.commerceCard.promotion.learnmore']}}

Please note: We are reviewing Western blot images included in the antibody testing data in our catalog, including those provided by third parties. Unless expressly labeled or annotated as “raw-unedited”, Western blot images included in the antibody testing data in our catalog may have been edited, optimized or otherwise adjusted for presentation.
产品信息
PA5-82649
种属反应
宿主/亚型
分类
类型
抗原
偶联物
形式
浓度
规格
纯化类型
保存液
内含物
保存条件
运输条件
RRID
产品详细信息
Immunogen sequence: VKETEARFPD VANGFIEEII HFKNYYDLNV LCNFLLENPD YPKREDRIII NPSSSLLASQ DETKLPKIDF FDYSKLTPLD
Highest antigen sequence indentity to the following orthologs: Rat - 91%, Mouse - 90%.
靶标信息
Activation of NF-κB as a result of Toll-like receptor (TLR) and IL-1 receptor signaling is a major component of innate immune responses. Signals from these receptors are relayed by a number of adapter molecules such as TRIF, TIRAP, and MyD88. Several regulatory mechanisms exist to control TLR signal transduction, including the inhibition of TLR expression and signaling by molecules such as ST2 and SIGIRR. Another mechanism is by the ubi-quitinization of selected TLRs by TRIAD3A, an E3 ubiquitin-protein ligase. TRIAD3A is a RING finger protein that can bind to TLR4 and TLR9, and to a lesser extent TLR3 and TLR5, catalyzing the ubiquitization of these molecules. Overexpression of TRIAD3A promoted the nearly complete degradation of TLR4 and TLR9; this reduction was reflected in the decreased signal-specific activation by ligands specific for these TLRs. Conversely, depletion of TRIAD3A resulted in enhanced TLR activation.
仅用于科研。不用于诊断过程。未经明确授权不得转售。
篇参考文献 (0)
生物信息学
蛋白别名: E3 ubiquitin-protein ligase RNF216; RING finger protein 216; RING-type E3 ubiquitin transferase RNF216; Triad domain-containing protein 3; triad3a; Ubiquitin-conjugating enzyme 7-interacting protein 1; Zinc finger protein inhibiting NF-kappa-B
基因别名: RNF216; TRIAD3; UBCE7IP1; ZIN
Entrez Gene ID: (Human) 54476




